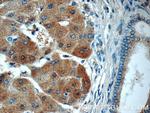
USP11 Antibody in Immunohistochemistry (Paraffin) (IHC (P))

Search
Proteintech
USP11 Polyclonal Antibody
{{$productOrderCtrl.translations['antibody.pdp.commerceCard.promotion.promotions']}}
{{$productOrderCtrl.translations['antibody.pdp.commerceCard.promotion.viewpromo']}}
{{$productOrderCtrl.translations['antibody.pdp.commerceCard.promotion.promocode']}}: {{promo.promoCode}} {{promo.promoTitle}} {{promo.promoDescription}}. {{$productOrderCtrl.translations['antibody.pdp.commerceCard.promotion.learnmore']}}
产品信息
22340-1-AP
种属反应
已发表种属
宿主/亚型
分类
类型
抗原
偶联物
形式
浓度
规格
纯化类型
保存液
内含物
保存条件
运输条件
产品详细信息
Immunogen sequence: YLSVPLLIS HKRVLEVFFI PMDPRRKPEQ HRLVVPKKGK ISDLCVALSK HTGISPERMM VADVFSHRFY KLYQLEEPLS SILDRDDIFV YEVSGRIEAI EGSREDIVVP VYLRERTPAR DYNNSYYGLM LFGHPLLVSV PRDRFTWEGL YNVLMYRLSR YVTKPNSDDE DDGDEKEDDE EDKDDVPGPS TGGSLRDPEP EQAGPSSGVT NRCPFLLDNC LGTSQWPPRR RRKQLFTLQT VNSNGTSDRT TSPEEVHAQP YIAIDWEPEM KKRYYDEVEA EGYVKHDCVG YVMKKAPVRL QECI (441-743 aa encoded by B C000350)
靶标信息
USP11 (ubiquitin specific peptidase 11), also known as UHX1, is a 920 amino acid deubiquitinating enzyme that participates in the Ub pathway. Localized to the nucleus, USP11 associates with both Ran BP-M (Ran binding protein M) and with the tumor suppressor BRCA2. Through these associations, USP11 functions to either inhibit ubiquitination of these proteins or to remove ubiquitin residues that have already been attached to these proteins. USP11 is implicated in several X-linked retinal diseases and, due to its ability to deubiquitinate BRCA2, may play a role in tumor suppression.
仅用于科研。不用于诊断过程。未经明确授权不得转售。
生物信息学
蛋白别名: deubiquitinating enzyme 11; RP4-659F15.2; ubiquitin carboxyl-terminal hydrolase, X-linked; ubiquitin thioesterase 11; ubiquitin thiolesterase 11; ubiquitin-specific processing protease 11; unnamed protein product
基因别名: UHX1
Entrez Gene ID: (Human) 8237